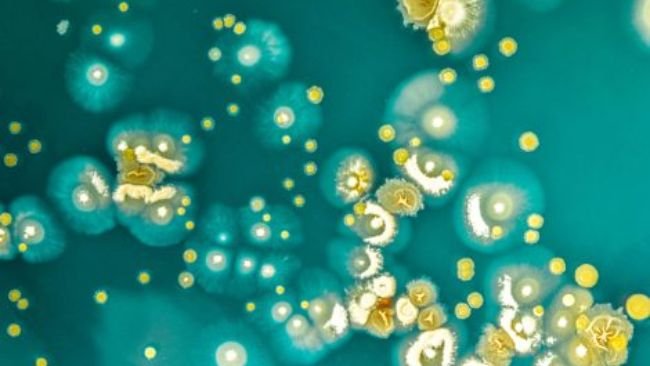

Alemanha: controlo do uso de antibióticos no sistema QS
Os resultados apresentados no relatório sobre o progresso mostram claramente que o uso de antibióticos diminuiu significativamente desde o início do acompanhamento e estabilizou ao longo dos anos a um nível que deveria corresponder ao mínimo terapeuticamente necessário.